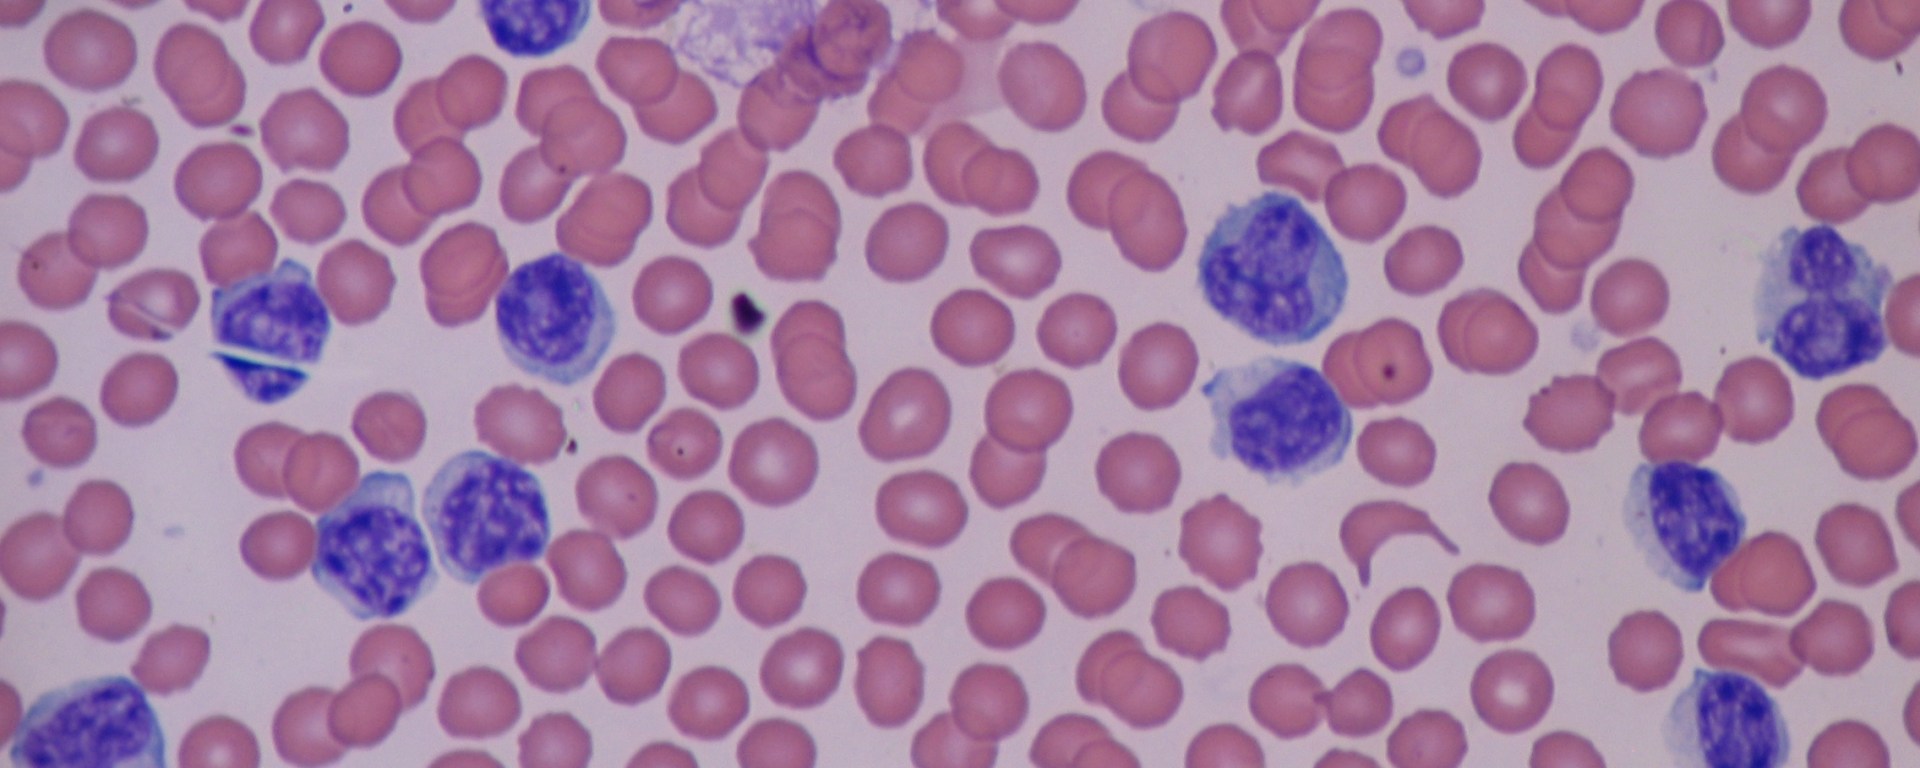

Hasta ahora se sabía que los linfocitos (las células más importantes de la inmunidad adaptativa) podían presentar únicamente solo un tipo de receptor en su membrana: un BCR (receptor de linfocitos B) o un TCR (receptor de linfocitos T); que sirven para ejecutar sus tareas, ya sea producir anticuerpos o encargarse de las células infectadas del organismo.
Sin embargo, un estudio publicado en mayo de 2019 encontró que había linfocitos con ambos receptores, a los que llamaron linfocitos DE (doble expresión) siendo la primera vez que se describen en la historia y cambiando el paradigma actual sobre la maduración de linfocitos. A continuación, todo lo que necesitas saber sobre estas recién descubiertas células:

- Los linfocitos DE no solo expresan tanto BCR como TCR, sino que además expresan otros genes característicos de los linfocitos B o T, junto con otros genes que no expresan ni los linfocitos B ni los T.
- Los linfocitos DE no solo expresan TCR como los linfocitos T, sino que este es funcional, y su activación supone la proliferación de estos linfocitos tal como lo haría con los T. Posteriormente también demostraron que sus BCR son moléculas funcionales.
- Aun en estos nuevos linfocitos lograron diferenciar dos subpoblaciones: los que expresan inmunoglobulina D y los que no; cada uno con un patrón de expresión de otras inmunoglobulinas.
- Otros marcadores usados para identificar las subpoblaciones de linfocitos T son CD4 (lo tienen los llamados cooperadores) y CD8 (lo tienen los citotóxicos). En los linfocitos DE también hay quienes expresan solo uno o ninguno de estos marcadores.
- La característica más importante de estos linfocitos es que fueron encontrados más frecuentemente en personas con diabetes tipo 1 (DT1) que en individuos sanos, y que además una mutación en una región determinante de las inmunoglobulinas se encontraba principalmente en estas células, a esta mutación la llamaron clonotipo X. Estudios adicionales comprobaron que el producto de dicha mutación es un autoantígeno (un compuesto propio del organismo que desencadena una reacción inmune como si fuera algo extraño) que se acompleja con DQ8 (un marcador que se ha encontrado en 90% de los pacientes con DT1) y juntos estimulan las células T CD4 de los pacientes con DT1 y no las de los individuos sanos.
Este estudio fue publicado en la revista Cell, el 30 de mayo del 2019 con el título A Public BCR Present in a Unique Dual-Receptor-Expressing Lymphocute from Type 1 Diabetes Patients Encodes a Potent T Cell Autoantigen y es encabezado por los doctores Rizwan Ahmed y Zahran Omidian del Departamento de Patología de la Escuela de Medicina de la Johns Hopkins University en Baltimore, Estados Unidos.